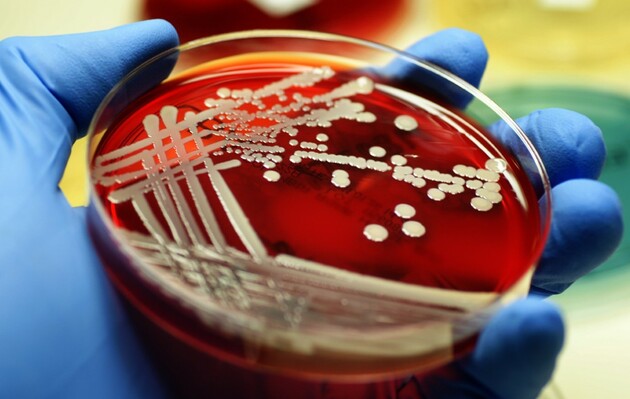

В образовательных учреждениях Украины снова будут проводить внезапные проверки для обследования работников на предмет золотистого стафилококка, сообщил министр здравоохранения Виктор Ляшко. Соответствующее решение приняли из-за отравления почти 100 школьников в Хмельницком.
«Такое решение было принято по результатам совещания у Президента Украины Владимира Зеленского о ситуации вокруг факта массового отравления детей в Хмельницком учебно-воспитательном объединении №1 «Школа-детский сад». Как показало расследование, проведенное специалистами Хмельницкого областного центра контроля и профилактики болезней Минздрава Украины, вспышка произошла в результате обсеменения золотистым стафилококком сырья и готовых блюд от работников пищеблока учреждения», - написал Ляшко в Facebook.
Поэтому, Минздрав будет инициировать проведение специализированными противоэпидемическими бригадами выборочных внезапных проверок для забора биоматериала, чтобы исследовать его на предмет наличия золотистого стафилококка. По словам Ляшко, бригады будут работать по всей территории страны.
«Президент Украины поручил Минэкономики, Минздраву, МОН и Госпродпотребслужбе отработать юридические механизмы проведения указанных внезапных проверок. Министерство здравоохранения дополнительно отрабатывает механизмы усиления контроля за качеством проведения медицинских осмотров в учреждениях здравоохранения и лабораториях», - подытожил Ляшко.
Напомним, с 8 по 10 сентября медучреждения Хмельницкого обнаружили симптомы отравления у 92 учеников младших классов и одной мамы ученика. Позже Хмельницкий областной центр контроля и профилактики болезней опубликовал результаты эпидисследования, согласно которому причиной отравления стал золотистый стафилококк.
Правоохранители сообщили о том, что из-за отравления детей в полицию обратились 39 родителей. По данным Нацполиции, информацию о первых четырех случаях госпитализации детей получили еще 7 сентября.